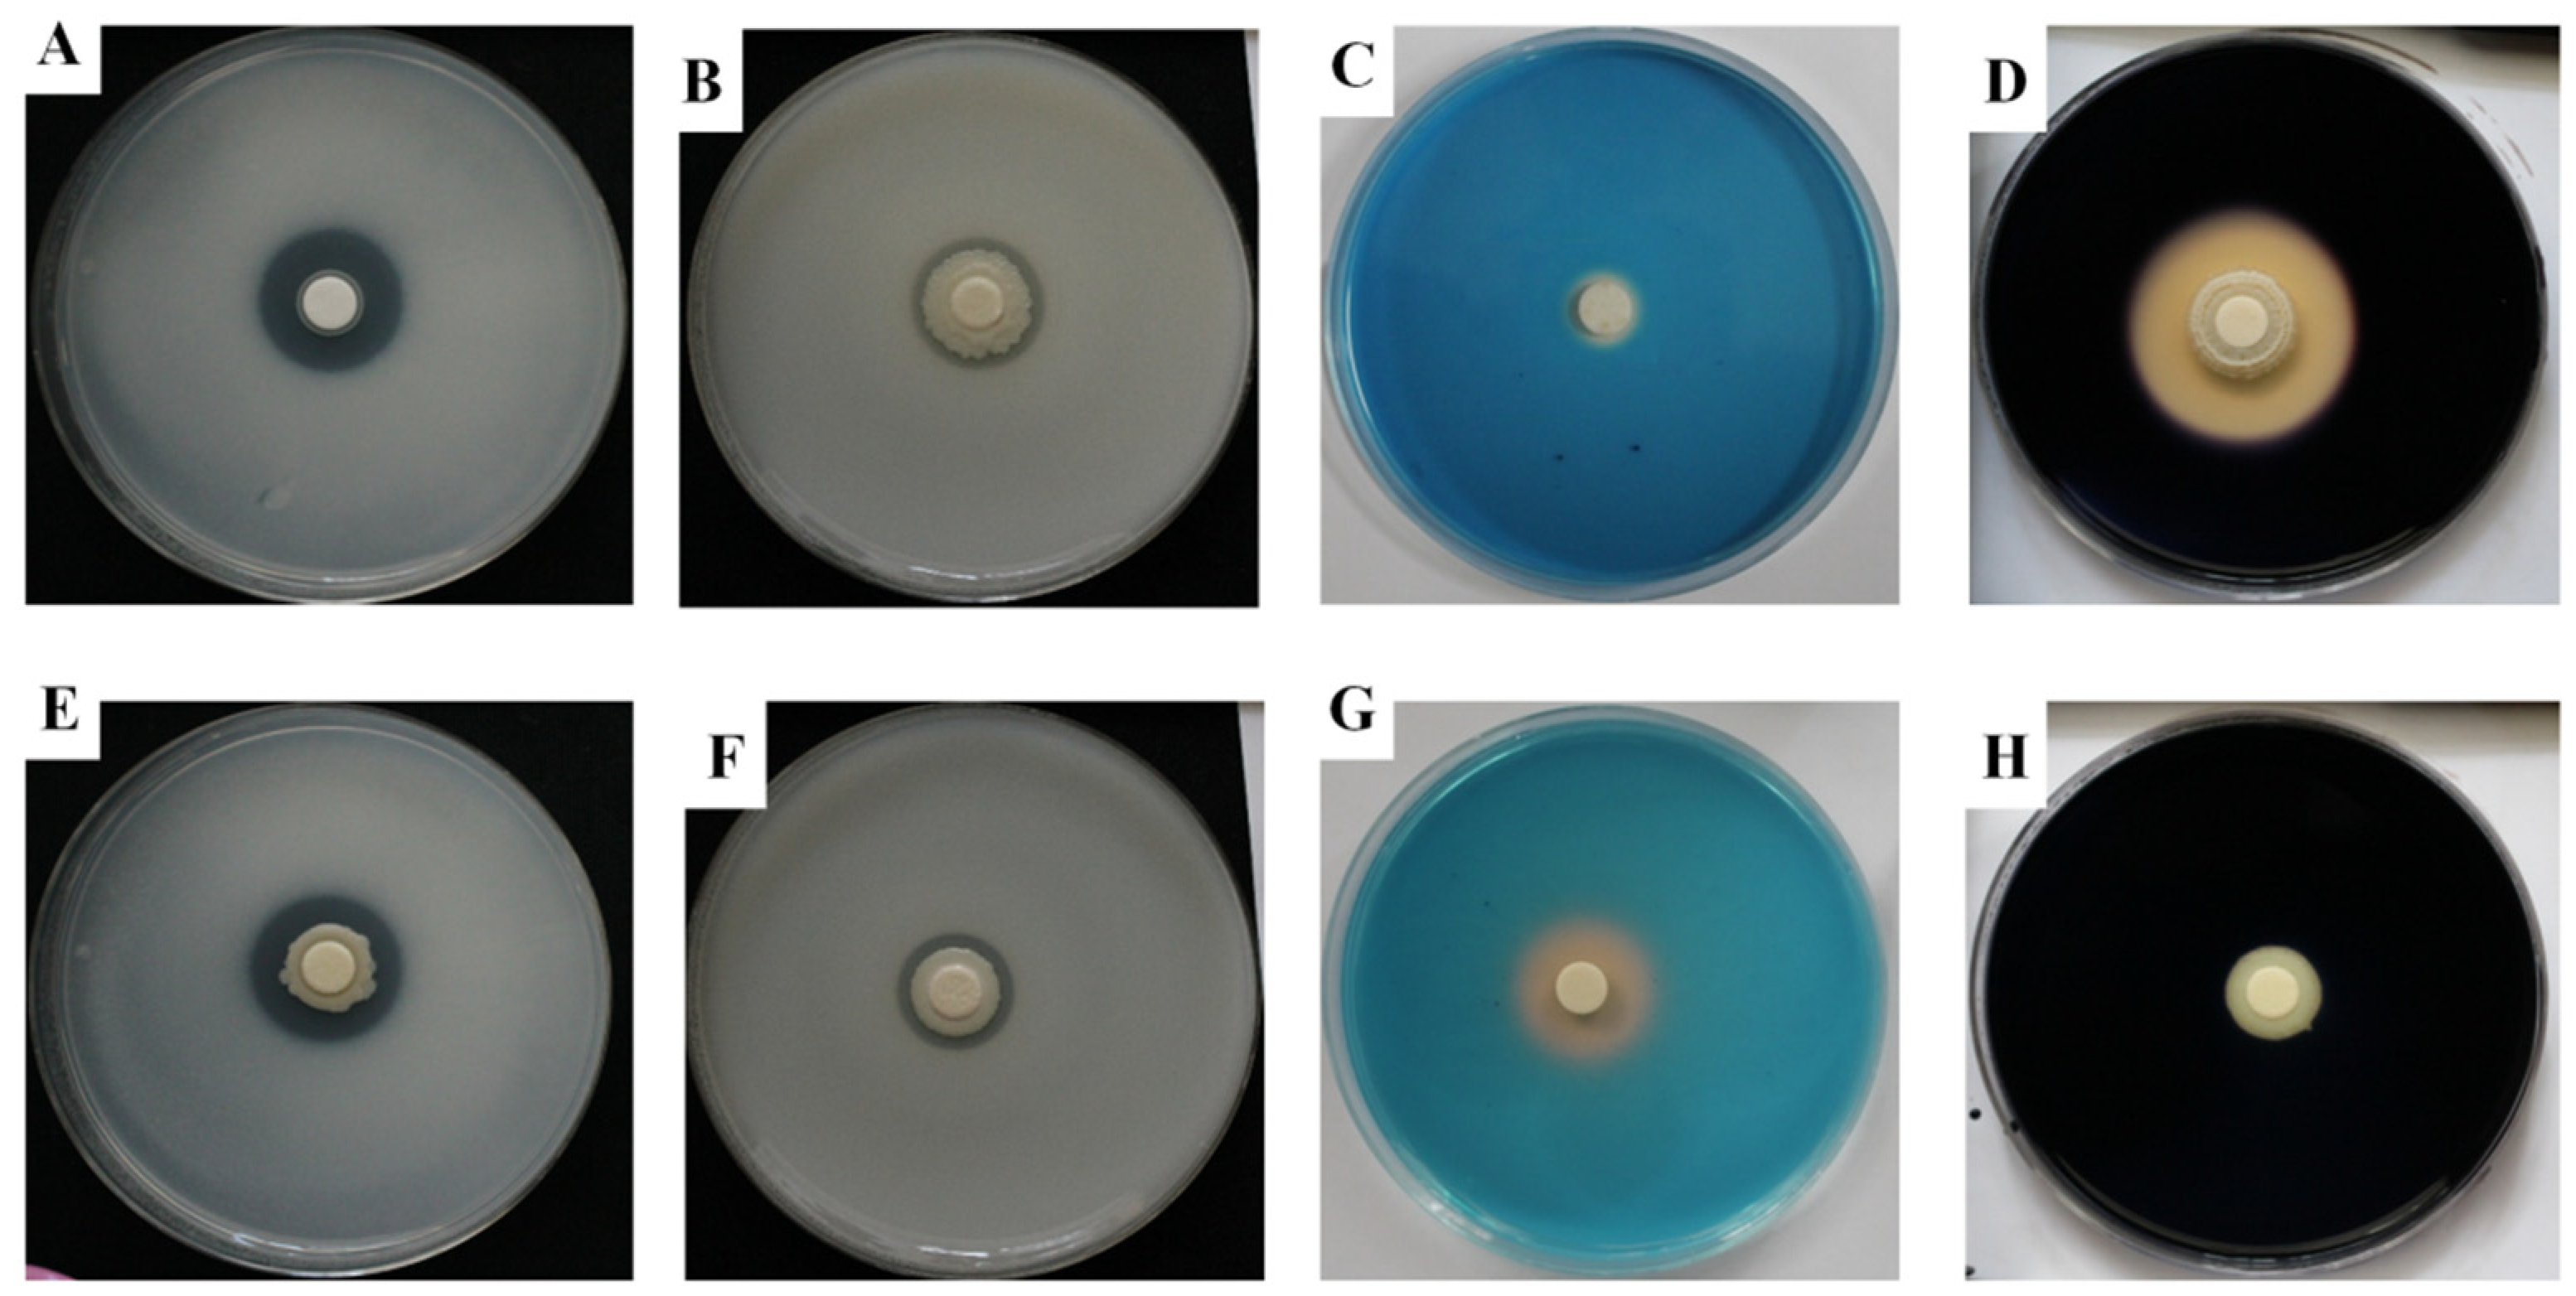
Ijms 20 01005 g003 Ijms 20 01005 g003

Abstract
In this study, two Burkholderia strains, strain KNU17BI2 and strain KNU17BI3, were isolated from maize rhizospheric soil, South Korea. The 16S rRNA gene and multilocus sequence analysis and typing (MLSA-MLST) were used for the identification of the studied strains. Strain KNU17BI2, which belonged to Burkholderia cenocepacia, was of a novel sequence type (ST) designated ST-1538, while strain KNU17BI3 had a similar allelic profile with the seven loci of Burkholderia contaminans strain LMG 23361. The strains were evaluated in vitro for their specific plant growth promoting (PGP) traits, such as zinc solubilization, phosphate solubilization, ammonia production, 1-aminocyclopropane-1-carboxylate (ACC) deaminase activity, indole acetic acid (IAA) production, siderophore, and hydrolytic enzyme activity. Interestingly, the strains exhibited a positive effect on all of the tested parameters. The strains also showed broad-spectrum antifungal activity against economically important phytopathogens in the dual culture assay. Furthermore, the strains were evaluated under greenhouse conditions for their in vivo effect to promote plant growth and to suppress the root rot of maize that is caused by Fusarium temperatum on four Korean maize cultivars. The results of the greenhouse study revealed that both of the strains were promising to significantly suppress fusarium root rot and enhance plant growth promotion on the four maize cultivars. This study, for the first time, reported in vitro antifungal potential of B. cenocepacia of novel ST against economically important plant pathogens viz., F. temperatum, Fusarium graminearum, Fusarium moniliforme, Fusarium oxysporum f.sp. melonis, Fusarium subglutinans, Phytophthora drechsleri, and Stemphylium lycopersici. This is also the first report of zinc solubilization by B. cenocepacia. Moreover, the present research work reports, for the first time, about the potential of B. cenocepacia and B. contaminans to control the root rot of maize that is caused by F. temperatum. Therefore, we recommend further studies to precisely identify the bioactive chemical compounds behind such activities that would be novel sources of natural products for biological control and plant growth promotion of different crops.
1. Introduction
Globally, Fusarium species cause several diseases of maize (Zea mays L.), such as seed rot, seedling blight, and stalk rot [1,2]. Fusarium temperatum has been reported to cause seed rot, seedling blight, and stalk rot of maize in different parts of the world [3,4], and it is necessary in the proper monitoring and control of disease in maize-growing areas [5].
Management of Fusarium root rot with chemicals has previously been reported [6,7]. However, due to environmental pollution and public concern, interest in the use of synthetic chemical fertilizers and pesticides has been exceedingly diminished [8]. Interestingly, the use of plant growth promoting rhizobacteria (PGPR), which plays a pivotal role in nutrient management, plant growth promotion, and disease management, has been increased [9]. Nevertheless, there is no information regarding the management of maize root rot that is caused by F. temperatum.
Members of the genus Burkholderia are the highly adaptable micro-organisms that can inhabit highly diverse ecological niches [10]. Interestingly, the Burkholderia species are able produce plenty of secondary metabolites, which are novel sources of bioactive compounds [11] with proteolytic [12] and lipolytic activities [13]. Furthermore, rhizospheric Burkholderia species have been reported to solubilize the phosphorus and zinc from insoluble sources [14,15]. More recently, several studies suggested the potential biotechnological application of Burkholderia species to promote plant growth and control plant diseases [16,17,18].
The genus Burkholderia was initially defined by Yabuuchi et al. [19] to accommodate seven species of the former rRNA group II pseudomonads. Currently, the genus Burkholderia comprises more than 100 species [20]. However, Burkholderia cepacia complex (Bcc) bacteria are highly closely related species, in which the similarity level of the 16S rRNA gene sequence is more than 97.5% [18]. Interestingly, the multilocus sequence-based approach has been emerged as a powerful tool to identify and type Bcc [18,21]. Thus, the present study aimed to identify the studied Burkholderia strains using multilocus sequence analysis and typing (MLSA-MLST), and to determine their biocontrol and plant growth promotion activity on four different Korean maize cultivars, namely Hikchal, Mibeak-2ho, Chahong-chal, and Oluckdehack-chal.
2. Results and Discussion
In this study, the biochemical and genetic characteristics of two Burkholderia strains viz., KNU17BI2 and KNU17BI3, which were isolated from maize rhizosphere in South Korea, were investigated.
2.1. Identification of Bacterial Isolates
According to BLAST-based search, 16S rRNA gene sequence of the studied strains, KNU17BI2 and KNU17BI3, had high similarity (99%) to the 16S rRNA gene sequences of reference Burkholderia species (data not shown). The phylogenetic relationship based on 16S rRNA gene sequence analysis showed that strain KNU17BI2 and strain KNU17BI3 were closely related to Burkholderia cenocepacia and Burkholderia contaminans in our phylogenetic tree, respectively (Figure 1). Thus, for a better identification of the studied strains from other closely related to reference Burkholderia species, multilocus sequence analysis and typing (MLSA-MLST) was performed. MLSA-MLST is the best option for the identification of the B. cepacia complex [18,22,23]. Thus, the phylogenetic tree that is inferred from MLSA revealed that the strain KNU17BI2 and strain KNU17BI3 belong to B. cenocepacia and B. contaminans, respectively (Figure 2). More importantly, the result of multilocus sequence typing (MLST) analysis revealed that the strain KNU17BI2 belongs to B. cenocepacia was of a novel sequence type (ST) that was designated ST-1538. The novel ST-1538 differs from other closely related sequence types by at least three loci in the allelic profile (Table 1). On the other hand, strain KNU17BI3, identified as B. contaminans, had a similar allelic profile when compared to all of the seven loci of B. contaminans with the sequence type 102 of the strain LMG23361 (Table 1). The MLST data of our strain KNU17BI2 of sequence type 1538, including the nucleotide sequences of each loci, allelic profiles, as well as sequence type, have been deposited in the Burkholderia cepacia complex PubMLST database at http://pubmlst.org/bcc. The isolation of B. cenocepacia and B. contaminans from rhizospheric soil has previously been reported [14,24]. However, this is the first report on the isolation of B. cenocepacia in maize rhizosphere in South Korea.

Figure 1.
Neighbor-joining phylogenetic analysis based on the 16S rRNA gene sequences of B. cenocepacia strain KNU17BI2 and B. contaminans strain KNU17BI3. Bootstrap values were determined based on 1000 trials and bootstrap values only >50 are indicated at branch nodes. The scale bar represents the number of nucleotide substitutions per site. Sequences of type species are indicated by a symbol (T).

Figure 2.
Phylogenetic tree based on MLSA of the concatenated nucleotide sequences of seven loci from the studied strains (B. cenocepacia strain KNU17BI2 and B. contaminans strain KNU17BI3) and reference strains of Burkholderia species. Values (>50%) that were based on 1000 bootstraps are shown at branch nodes. The scale bar represents the number of nucleotide substitutions per site. Sequences of type species are indicated by a symbol (T).

Table 1.
Allelic profile of the seven loci of strain KNU17BI2 and strain KNU17BI3 as compared with closely related strains of B. cenocepacia and B. contaminans.
2.2. In Vitro Plant Growth Promoting (PGP) Activity Assays
With regard to plant growth promoting traits, both of strains showed a promising effect. The results of phosphate solubilization assay revealed that the strains showed the ability to solubilize tricalcium phosphate (TCP) according to the formation of clear solubilization zone around its colony (Table 2 and Figure 3). Strain KNU17BI2 showed a higher phosphate solubilization index (SI) (2.3) as compared to strain KNU17BI3 (1.8) after 10 days of incubation. The phosphate solubilization index (SI) of both strains increased with the increasing incubation period (Table 2). The formation of the solubilized halo zone around the bacterial colonies may be due to the ability of the strains to produce phosphatase enzymes or other chemical compounds, such as organic acids and polysaccharides [25]. Similarly, the potentiality of B. cenocepacia to solubilize inorganic phosphates has been previously reported [26]. Phosphorus is the second most important nutrient after nitrogen for plant growth; however, only less than 5% of total soil phosphorus is found in available form to plants [27,28]. Thus, the ability to solubilize the insoluble phosphates is one of the most important features of plant growth promoting bacteria to enhance plant nutrition through an increase in phosphorus uptake by plants [29]. The application of phosphate solubilizing bacteria could contribute to the reduction of excessive fertilizers chemical usage and thereby reduce the harmful effects of fertilizers on the environment and human health [28].

Table 2.
Qualitative estimation of phosphate and zinc solubilization efficiency of the studied strains.

Figure 3.
(A,E) In vitro phosphate solubilization on national botanical research institute’s phosphate growth (NBRIP) plates (B,F) zinc solubilization on Pikovskaya (PVK) agar plates supplemented with an insoluble ZnO (1.244 g/L) (C,G) siderophore production, and (D,H) amylase activity after seven days of incubation (top = strain KNU17BI2, bottom = strain KNU17BI3).
In addition, the Zn solubilization assay result revealed that both strains had the potential to solubilize an insoluble zinc sources, ZnO (1.244 g·L−1) and ZnCO3, 1.913 g·L−1 in Pikovskaya (PVK) agar media. The Zn solubilization ability of strain KNU17BI2 was comparatively higher than KNU17BI3 on both tested zinc sources (Table 2 and Figure 3). In addition, both of the strains showed higher solubilization efficiency on ZnO amended PVK agar media than ZnCO3 media. These results comply with the previous studies [14,30] that Burkholderia species have the potential to solubilize the insoluble form of zinc. The solubilization potential may be attributed to the release of different chemical compounds, including gluconic acid and 2 keto gluconic acids [31]. Zn has the propensity to form insoluble complexes in the soil and become unavailable for plant uptake [32]. Thus, the lack of Zn is a continual challenge in crop production, being particularly in high pH soils, and its significant impact on human nutrition has been previously reported [33,34]. Interestingly, the solubilization of an insoluble soil Zn by bacterial inoculations has been reported to significantly increase in the total Zn uptake and thereby increase plant growth [32].
Both the studied strains developed yellow-orange halo around their colonies on blue Chrome Azurol S (CAS) agar medium signifying their ability to produce siderophore. Strain KNU17BI3 exhibited higher (23 mm) siderophore production, while KNU17BI2 exhibited very low siderophore (12 mm) after seven days of incubation (Figure 3). Similar to our study, previous studies [35,36] reported the potential of Burkholderia species to produce siderophores. A PGPR having siderophore production potential plays an important role in helping plants to acquire iron for optimal growth and it also offers competitive advantages to PGPR by suppressing the proliferation of plant pathogens [37,38].
The studied strains displayed positive results for ammonia production and IAA production. The amount of ammonia that is produced by strain KNU17BI3 was by far higher (14.1 μg·mL−1) than strain KNU17BI2 (6.3 μg·mL−1) after three days of incubation. In addition, both of the strains were able to produce IAA in LB medium, regardless of amendment of L-tryptophan (Figure 4). After three days of incubation, the amount of IAA production by strain KNU17BI3 in LB medium without the amendment of l-tryptophan was higher (7.9 μg·mL−1) when compared to KNU17B2 (6.1 μg·mL−1) (Figure 4). In l-tryptophan amended LB medium, the amount of IAA was increased as L-tryptophan concentration increased in both strains (Figure 4). The maximum IAA (26.6 7.9 μg·mL−1) was produced by strain KNU17BI3 at higher l-tryptophan concentration (2.0 μg·mL−1). Indole-3-acetic acid (IAA) and ammonia are produced by many plant-associated bacteria that can enhance plant growth [39,40] with enhanced water and nutrients uptake [41].

Figure 4.
Effect of l-tryptophan concentration on indole acetic acid (IAA) production by strain KNU17BI2 and strain KNU17BI3 assessed after three days of incubation. The vertical bars indicate the standard error of three replications.
The strains exhibited fast and luxuriant growth colonies on DF-agar plate that was supplemented with 3mM ACC as the unique nitrogen source (data not shown). This signifies ACC deaminase activity of the strains, as they were capable of using ACC as a nitrogen source. Our result complies with previous reports [42,43] that ACC deaminase is the widespread enzyme in diverse Burkholderia species, including B. caryophylli, B. cenocepacia, and B. contaminnans. Furthermore, strain KNU17BI2 exhibited a positive reaction for amylase, while strain KNU17BI3 did not show the activity (Figure 3). Amylase activity can help PGPR to easily hydrolyze the cell wall of phytopathogens [44].
2.3. In Vitro Antifungal Activity
In the dual-culture assay, the antagonistic activity of strain KNU17BI2 and strain KNU17BI3 were tested against F. temperatum, maize root rot pathogen. The results revealed that both of the strains were effective in inhibiting the mycelial growth of F. temperatum (Table 3). The strains were further tested for their broad-spectrum activity against eight important phytopathogens (Table 3). The results showed that both of them had strong antifungal activity against all of the tested phytopathogens (Table 3 and Figure 5). The zone of inhibition around the tested plant pathogens (Figure 5) by the studied strains may be attributed to the ability of the strains to produce toxin metabolites, proteolytic enzymes, and siderophore [36,45]. Previous studies [14,15] reported the biocontrol potential of Burkholderia species, including B. cepacia and B. contaminans against several phytopathogens. However, the antifungal activity of B. cenocepacia against Fusarium graminearum, Fusarium moniliforme, Fusarium oxysporum f.sp. melonis, Fusarium subglutinans, F. temperatum, Phytophthora drechsleri, and Stemphylium lycopersici has not previously been reported. F. graminearum, F. moniliforme, and F. subglutinans are destructive disease of cereals that cause yield loss and grain quality due to their associated toxic metabolites [46,47]. P. drechsleri is one of the most devastating plant pathogen causing sever root rot in various crops [48,49]. S. lycopersici is an emerging plant pathogen causing leaf spot, stem rot, and fruit rot in various commercial crops [50,51,52]. This generally shows the essence of exploiting B. cenocepacia and B. contaminans for the control of the aforementioned pathogens, which causes huge economic loss in different crops.

Table 3.
Broad spectrum antifungal activity of the study Burkholederia strains.

Figure 5.
In vitro antifungal activity of the isolated Burkholederia strains against different phytopathogens in the dual culture: (A) A. alternate, (B) F. graminearum, (C) F. moniliforme, (D) F. oxysporum f.sp. melonis, (E) F. subglutinans, (F) F. temperatum, (G) P. drechsleri, and (H) S. lycopersici (top = B. cenocepacia strain KNUBI2, bottom = B. contaminans strain KNUBI3).
2.4. SEM Analysis
Scanning electron microscope was used to examine any morphological defects from the edges of the inhibitory clear zone of the tested phytopathogens due to the studied strains. The SEM analysis revealed that the studied strains caused serious defects in the hyphal morphology of the selected phytopathogens, while hyphae from the untreated control were intact with normal morphology. The studied strains caused the hyphae of the phytopathogens to shrink, lyse, and deform (Figure 6). Similar to our study, such morphological defects in an interaction between bacterial strains and fungi in a dual culture have previously been reported [53]. However, to the best of our knowledge, the deleterious effects of B. cenocepacia against F. moniliforme, F. subglutinans, and F. temperatum have not previously been reported.

Figure 6.
Scanning electron micrographs of (A,D,G) F. moniliforme, (B,E,H) F. subglutinans and (C,F,I) F. temperatum (A–C = treated with strain KNU17BI2, D–F = treated with strain KNU17BI3, G–I = untreated control), (scale bars: 20 μm). (A) White arrows denote shrinked, deformed and/or lysed fungal structures.
2.5. Greenhouse Experiments
2.5.1. Effect of Strain KNU17BI2 and Strain KNU17BI3 on Virulence of F. temperatum
The influence of KNU17BI2 and KNU17BI3 in reducing the virulence of F. temperatum on the seedlings of four maize cultivars viz., Hikchal, Mibeak-2ho, Chahong-chal, and Oluckdehack-chal was assessed after 30 days of planting. Subsequently, typical symptoms that were caused by the root rot pathogen, F. temperatum, were observed on pathogen-inoculated plants, as indicated by discolored primary and secondary roots [54,55] (Figure 7). The severity data showed that root rot disease was significantly reduced in all of the tested Korean maize cultivars following the soil drenching of the studied strains (Figure 8). To the contrary, non-bacterized plants, but pathogen-challenged (negative control treatment), had the highest F. temperatum-induced root rot severity (Figure 7 and Figure 8). The development of healthy roots on bacterized plants of each cultivar may be due to the direct effect of the Burkholderia strains on pathogen, F. temperatum [56]. Similar to our result, previous studies [7,57] reported the potential of PGPR to suppress maize root diseases. Burkholderia cepacia has been reported to suppress Pythium damping-off of sweet corn through lysis of zoospores and the prevention of cyst germination and germ tube growth [57]. Furthermore, Omar and his co-workers [58] demonstrated the bio-control capacity of Burkholderia cepacia against Fusarium crown and root rot of. However, no previous study has reported the potential of B. cenocepacia and B. contaminans to control root rot of maize that is caused by F. temperatum. Among, the four maize verities tested, root rot severity was comparatively higher on cv. Hikchal than cv. Mibeak-2ho (Figure 7 and Figure 8). This is the first report showing the reaction of Korean maize cultivars to the root rot causing pathogen, F. temperatum.

Figure 7.
Pictorial view of roots of Korean maize cultivars infected with F. temperatum (A,E,I) Hikchal, (B,F,J) Mibeak-2ho, (C,G,K) Chahong-chal and (D,H,L) Oluckdehack-chal (A–D = negative control, E–H = treated with strain KNU17BI2, I–L = treated with strain KNU17BI3). Non-bacterized plants but pathogen-challenged were served as negative control.

Figure 8.
Effectiveness of strain KNU17BI2 and strain KNU17BI3 for the control of root rot of maize caused by F. temperatum in greenhouse. Percent severity index (mean of three replications having 10 plants per replication) assessed 30 days after treatment. Mean values having the same letter(s) in each cultivar are not statistically different (p ≤ 0.05) according to DMRT test. Non-treated plants (neither pathogen, nor Burkholderia strains) were served as non-treated control and non-bacterized plants, but pathogen-challenged were served as negative control.
2.5.2. Plant Growth Promotion Effect of Strain KNU17BI2 and Strain KNU17BI3
The result of our study revealed that F. temperatum highly affected the negative control plants, thereby significantly reducing the shoot growth and amount of total chlorophyll content (Figure 9). On the other hand, plants that were treated with either of the strains had a highly significant positive effect on all plant growth parameters that were tested viz., total chlorophyll content, plant height, shoot dry weight, and root dry weight in all maize cultivars (Figure 9 and Figure 10). Similar to our study, previous studies [1,4] reported that seedling chlorosis, reduction in shoot growth, and fresh weight were observed on maize that was growing in F. temperatum inoculated soil. Furthermore, previous reports [1,59,60] explained that the degree of virulence by F. temperatum was defined as the inhibition of shoot elongation and chlorosis symptoms. More importantly, the increase in all tested plant growth parameters may be due to the plant growth promoting traits that the strains possess. In addition, the plant growth promotion effect of Burkholderia species on maize plant has been previously reported [14,61]. It is worth to note that B. cenocepacia has been reported as plant-beneficial endophytic bacterium to control Fusarium wilt of banana [62,63]. However, this is the first report demonstrating the bio-control potential of B. cenocepacia and B. contaminans against root rot of maize that is caused by F. temperatum.

Figure 9.
Effect of strain KNU17BI2 and strain KNU17BI3 on (A–D) total chlorophyll content and (E–H) plant height of Korean maize cultivars (left to right = Hikchal, Mibeak-2ho, Chahong-chal, and Oluckdehack-chal) after 30 days of planting. Mean values having the same letter(s) in each cultivar are not statistically different (p ≤ 0.05) according to the DMRT test. Non-treated plants (neither pathogen, nor Burkholderia strains) were served as non-treated control and non-bacterized plants, but pathogen-challenged were served as negative control.

Figure 10.
Effect of strain KNU17BI2 and KNU17BI3 on root and shoot biomass of Korean maize cultivars after 30 days of planting. Mean values having the same letter(s) in each cultivar are not statistically different (p ≤ 0.05) according to DMRT test. Non-treated plants (neither pathogen, nor Burkholderia strains) were served as non-treated control and non-bacterized plants, but pathogen-challenged were served as negative control.
In conclusion, MLSA-MLST revealed that strain KNU17BI2, which belongs to B. cenocepacia, was of a novel sequence type (ST) designated ST-1538. On the other hand, strain KNU17BI3, identified as B. contaminans, had similar allelic profile when compared to all seven loci of B. contaminans strain LMG 23361 with a sequence type 102. The current study reported two multi-trait bacterial strains viz., B. cenocepacia strain KNU17BI2 and B. contaminans strain KNU17BI3 possessing promising in vitro PGP traits, such as zinc solubilization, phosphate solubilization, ammonia production, 1-aminocyclopropane-1-carboxylate (ACC) deaminase activity, indole acetic acid (IAA) production, siderophore, and hydrolytic enzyme activity. This study is the first report on the strong in vitro antifungal activity of B. cenocepacia strain KNU17BI2 of novel ST against several economically important plant fungal pathogens. These include, against F. temperatum, F. graminearum, F. moniliforme, F. oxysporum f.sp. melonis, F. subglutinans, P. drechsleri, and S. lycopersici. In our study, root drenching of plants of four maize cultivars with the studied strains lead to an increase in the growth of the four maize cultivars and a significant positive effect in the control of root rot of maize seedlings on four different maize cultivars. The present research work reports, for the first time, the potential of B. cenocepacia and B. contaminans to control root rot of maize that is caused by F. temperatum. Hence, further studies are needed to precisely identify the prevailing bioactive chemical compounds behind such activities that would be novel sources of natural products for plant growth promotion as well as biological control.
3. Materials and Methods
3.1. Microbial Sources
In this study, two bacterial strains (strain KNU17BI2 and strain KNU17BI3) were isolated from maize rhizosphere soil that was located in Gangwon-do province (37°86′ N, 127°75′ E), South Korea. For subsequent experiments, inoculum suspensions of each strain were grown in a tryptic soy broth (TSB) medium on a shaking incubator at 150 rpm in the dark at 28 ± 2 °C for 48 h. To harvest the bacterial cells, the growing media was centrifuged (6000 rpm, 5 min) and the bacterial cells were washed five times using phosphate-buffered saline solution (PBS; 5 mM K2HPO4, 150 mM NaCl, pH 7.0). Subsequently, the inoculum concentration of each strain was adjusted to 108 cells·mL−1.
The study phytopathogens were obtained from Korean agricultural culture collection (KACC), South Korea. The phytopathogens were: A. alternate (KACC43921), F. graminearum (KACC47499), F. moniliforme (KACC41032), F. oxysporum f.sp. melonis (KACC47669), P. drechsleri (KACC40190), and S. lycopersici (KACC40967). F. temperatum and F. subglutinans were kindly provided by Prof. Kim Kyoung Su, Kangwon National University, South Korea. The tested phytopathogens were maintained on potato dextrose agar (PDA) plates at 4 °C for further experimental use and mycelia colonized PDA plugs (8 mm) of the pathogens from the edge of culture plate were used in all of the experiments.
3.2. Identification of Bacterial Isolates
16S rRNA Gene Sequencing
Almost the full-length 16S rRNA gene sequences were PCR amplified with the universal primers 27f (5′-AGAGTTTGATCATGGCTCAG-3′) and 1492R (5′-TACGGYTACCTTGTTACGACTT-3′) [64]. Sequencing was carried out at Macrogen Inc. (Seoul, South Korea) using a 3730XL DNA sequencer (Applied BioSystems, Waltham, CA, USA). The search for sequence similarity was carried out using the BLAST server (http://www.ncbi.nlm.nih.gov/BLAST/). The phylogenetic tree of 16S rRNA gene was constructed by the neighbor-joining method using Kimura’s two-parameter model [65] that was implemented in the MEGA 6 software [66]. A bootstrap confidence analysis was performed with bootstrap 1000 replicates.
3.3. Multilocus Sequencing Analysis and Typing (MLSA-MLST)
The studied strains were further studied by MLSA. In this analysis, the primers of the seven loci were used following the method of Spilker et al. [22]. The concatenated sequence of MLSA (2773 bp) were constructed as: atpD (443 bp), gltB (400 bp), gyrB (454 bp), recA (393 bp), lepA (397 bp), phaC (385 bp), and trpB (301 bp). The concatenated sequences of each studied strain and the reference strain were used to construct the phylogenetic tree using MEGA6.0 [66]. For MLST, all seven housekeeping gene (atpD, gltB, gyrB, recA, lepA, phaC and trpB) sequences of the studied strains were compared to reference strains available in the Burkholderia cepacia complex PubMLST database (https://pubmlst.org/bcc/).
3.4. Genbank Accession Numbers
The nucleotide sequences of each allelic profiles and the sequence type of strain KNU17BI2 are found at the Burkholderia cepacia complex PubMLST database (http://pubmlst.org/bcc) with sequence type (ST) 1538. In addition, the nucleotide sequences of 16S rRNA gene and each MLSA-MLST loci of strain KNU17BI2 and strain KNU17BI3 have been deposited in GenBank/EMBL/DDBJ (Table 4).

Table 4.
Genebank accession numbers of strain KNU17BI2 and KNU17BI3.
3.5. In Vitro Antifungal Activity
The broad-spectrum inhibitory activity of the studied strains was tested in vitro against seven different economically important plant fungal pathogens using dual culture technique on PDA. These were: F. temperatum, A. alternate, F. graminearum, F. moniliforme, F. oxysporum f.sp. melonis, P. drechsleri, and S. lycopersici. After five days of incubation at 28 ± 2 °C, the inhibitory activity of the strains was determined as the length of the zone of mycelial growth inhibition between the bacterial colony and the test phytopathogen. The percent inhibition of mycelial growth of the tested phytopathogens was calculated based on the formula: PI = (C − T)/C × 100, where PI is the inhibition of mycelial growth in percent, C is the radial growth of the phytopathogen in control, and T is the radial growth of the phytopathogen in dual culture. The experiment was carried out in three replications and the experiment was repeated three times.
3.6. Scanning Electron Microscope (SEM) Analysis
To study the interaction of the selected phytopathogens (F. moniliforme, F. subglutinans, and F. temperatum) and the studied strains, the mycelia of the phytopathogens from the edge of the halo zone in the dual culture Petri plates were taken and then observed under scanning electron microscope (SEM). The mycelia samples were prepared by thin coating with gold and palladium (60:40). The coated mycelia samples were observed under SEM (LEO Model 1450VP Variable Pressure Scanning Electron Microscope; Carl Zeiss, Cambridge, MA, USA).
3.7. In Vitro Plant Growth Promoting (PGP) Activity Assays
The strains were also tested for important traits of plant growth promotion activity. The traits were: phosphate solubilization, zinc solubilization, indole-3-acetic acid (IAA) production, ammonia production, and siderophore production. For each trait, the experiments were conducted in triplicates and the experiment was repeated three times.
Phosphate solubilizing ability of the studied strains was assessed on national botanical research institute’s phosphate growth (NBRIP) medium that was supplemented with tricalcium phosphate (TCP). In addition, the zinc solubilizing potential of the strains was determined on PVK medium supplemented with an insoluble zinc sources containing 1% zinc (ZnO, 1.244 g·L−1 and ZnCO3, 1.913 g·L−1). After seven days of incubation at 28 ± 2 °C, the diameter of the clear zone around the bacterial colonies was measured. The solubilization index (SI) of phosphate and zinc by the studied strains was determined as the ratio between the halo zone diameter and the colony diameter.
The potential of the studied strains to produce ammonia was determined following the method of Cappuccino and Sherman [67]. The amount of ammonia produced was spectrophotometrically determined (UV–1800, Shimadzu Corporation, Kyoto, Japan) from the standard curve of ammonium sulfate (0–10 µmol·mL−1). The method of Gordon and Weber [68] was employed to determine the potential of the tested strains to produce indole acetic acid (IAA). The concentration of IAA in culture was determined while using a standard curve of IAA that was prepared by diluting pure IAA (Sigma-Aldrich, St. Loise, MO, USA) in LB medium at various concentrations (0 to 2 mg·mL−1). The strains were also qualitatively tested for the aminocyclopropane-1-carboxylate (ACC) deaminase activity on Dworkin and Foster (DF) minimal salt medium amended with 3 mM filter sterilized ACC as the sole nitrogen source [69]. Amylase activity was determined on starch agar plates [67].
3.8. Greenhouse Experiments
Strain KNU17BI2 and strain KNU17BI3 were further evaluated for biological control of maize root rot on four Korean maize cultivars under greenhouse conditions. The cultivars were Hikchal, Mibeak-2ho, Chahong-chal, and Oluckdehack-chal. In this study, four mycelia colonized PDA plugs (8 mm) of F. temperatum were mixed with the top 5 cm of soil in each plastic pot (10 cm diameter) [70]. After 24 h of pathogen inoculation, the seeds of each cultivar were planted at a depth of approximately 4 cm (one seed per pot). Subsequently, one milliliter of bacterial inoculum adjusted at a concentration of 108 cells·mL−1 was applied to seeds of each cultivar prior to covering with soil. Non-treated plants (neither pathogen, nor Burkholderia strains) were served as non-treated control and non-bacterized plants, but the pathogen-challenged were served as negative control. In this experiment, treatments (single Burkholderia strains, non-treated control, and negative control) were arranged in a completely randomized design (CRD) with three replications with 10 plants per replication, and the experiment was repeated twice.
3.9. Assessment of Effect of Burkholderia Strains on Virulence of F. temperatum
The effect of strain KNU17BI2 and strain KNU17BI3 in controlling the root rot of maize due to F. temperatum on the four Korean maize cultivars was assessed after 30 days of planting. Disease scaling of root rot that is caused by F. temperatum was done based on a 0–4 scale, where 0 = 0, healthy root; 1, less than 25% of the root spoiled due to rotting; 2, 25–50% of the root spoiled, evident from dropping of the leaves during daytime; 3, up to 75% of the root damaged, as evident from starting of wilt and drying of leaves from bottom to top; and, 4, complete rotting of the root, completely wilted, dead, and dry plants [57]. For analysis, the scale was converted into the percentage severity index (PSI) [71].
Furthermore, based on previous studies [37,38], the degree of virulence that is caused by F. temperatum was defined as the inhibition of shoot elongation and chlorosis symptoms. Hence, leaf chlorosis that was based on total chlorophyll content (SPAD unit) was measured using chlorophyll-meter SPAD 502 (Konica Minolta, Tokyo, Japan) from the middle leaf of each plant. Morphological data, including shoot and root dry weight (oven dried at 65 °C for 72 h), were also recorded.
3.10. Statistical Data Analysis
Analysis of variance (ANOVA) of all experimental data was carried out using SAS software version 9.2 [72]. All of the experiments of in vitro and greenhouse were conducted in three replications and were repeated twice. The results of the experiments were expressed as mean ± standard error. Mean separation was carried out using the multiple comparison procedure and Duncan’s multiple range test (DMRT) at p ≤ 0.05.
Author Contributions
Conceptualization, S.B.T. and Y.S.L.; Methodology, S.B.T., S.W.K., H.G.L. and Y.S.L.; Software, S.B.T., S.W.K., and Y.S.L.; Validation, S.B.T., S.W.K., H.G.L. and Y.S.L.; Formal Analysis, S.B.T., S.W.K., and Y.S.L.; Investigation, S.B.T., S.W.K., H.G.L. and Y.S.L.; Resources, Y.S.L.; Data Curation, S.B.T. and Y.S.L.; Writing-Original Draft Preparation, S.B.T. and Y.S.L.; Writing-Review & Editing, S.B.T. and Y.S.L.; Visualization, S.B.T. and Y.S.L.; Supervision, S.B.T., S.W.K., H.G.L. and Y.S.L.; Project Administration, H.G.L. and Y.S.L.; Funding Acquisition, Y.S.L.
Funding
This research was financially supported by University Industry Cooperation Foundation of Kangwon National University.
Conflicts of Interest
The authors declare no conflict of interest.
References
- Varela, C.P.; Casal, O.A.; Padin, M.C.; Martinez, V.F.; Oses, M.S.; Scauflaire, J.; Munaut, F.; Castro, M.B.; Vázquez, J.M. First report of Fusarium temperatum causing seedling blight and stalk rot on maize in Spain. Plant Dis. 2013, 97, 1252. [Google Scholar] [CrossRef] [PubMed]
- Czembor, E.; Stępień, Ł.; Waśkiewicz, A. Fusarium temperatum as a new species causing ear rot on maize in Poland. Plant Dis. 2014, 98, 1001. [Google Scholar] [CrossRef] [PubMed]
- Shin, J.H.; Han, J.H.; Lee, J.K.; Kim, K.S. Characterization of the maize stalk rot pathogens Fusarium subglutinans and F. temperatum and the effect of fungicides on their mycelial growth and colony formation. Plant Pathol. J. 2014, 30, 397. [Google Scholar] [PubMed]
- Lanza, F.E.; Mayfield, D.A.; Munkvold, G.P. First report of Fusarium temperatum causing maize seedling blight and seed rot in North America. Plant Dis. 2016, 100, 1019. [Google Scholar] [CrossRef]
- Wang, J.H.; Zhang, J.B.; Li, H.P.; Gong, A.D.; Xue, S.; Agboola, R.S.; Liao, Y.C. Molecular identification, mycotoxin production and comparative pathogenicity of Fusarium temperatum isolated from maize in China. J. Phytopathol. 2014, 162, 147–157. [Google Scholar] [CrossRef]
- Reid, T.C.; Hausbeck, M.K.; Kizilkaya, K. Use of fungicides and biological controls in the suppression of Fusarium crown and root rot of asparagus under greenhouse and growth chamber conditions. Plant Dis. 2002, 86, 493–498. [Google Scholar] [CrossRef]
- Figueroa-López, A.M.; Cordero-Ramírez, J.D.; Martínez-Álvarez, J.C.; López-Meyer, M.; Lizárraga-Sánchez, G.J.; Félix-Gastélum, R.; Castro-Martínez, C.; Maldonado-Mendoza, I.E. Rhizospheric bacteria of maize with potential for biocontrol of Fusarium verticillioides. SpringerPlus 2016, 5, 330. [Google Scholar] [CrossRef] [PubMed]
- Vejan, P.; Abdullah, R.; Khadiran, T.; Ismail, S.; Nasrulhaq Boyce, A. Role of plant growth promoting rhizobacteria in agricultural sustainability—A review. Molecules 2016, 21, 573. [Google Scholar] [CrossRef] [PubMed]
- Shrivastava, P.; Kumar, R. Soil salinity: A serious environmental issue and plant growth promoting bacteria as one of the tools for its alleviation. Saudi J. Biol. Sci. 2015, 22, 123–131. [Google Scholar] [CrossRef] [PubMed]
- Coenye, T.; Vandamme, P. Diversity and significance of Burkholderia species occupying diverse ecological niches. Environ. Microbiol. 2003, 5, 719–729. [Google Scholar] [CrossRef] [PubMed]
- Gouda, S.; Das, G.; Sen, S.K.; Shin, H.S.; Patra, J.K. Endophytes: A treasure house of bioactive compounds of medicinal importance. Front. Microbial. 2016, 29, 1538. [Google Scholar] [CrossRef] [PubMed]
- Lee, J.W.; Kim, Y.E.; Park, S.J. Burkholderia alba sp. nov., isolated from a soil sample on Halla mountain in Jeju island. J. Microbiol. 2018, 56, 312–316. [Google Scholar] [CrossRef] [PubMed]
- Carvalho-Gonçalves, L.C.; Gorlach-Lira, K. Lipases and biosurfactants production by the newly isolated Burkholderia sp. Braz. J. Biol. Sci. 2018, 30, 57–68. [Google Scholar] [CrossRef]
- Tagele, S.B.; Kim, S.W.; Lee, H.G.; Kim, H.S.; Lee, Y.S. Effectiveness of multi-trait Burkholderia contaminans KNU17BI1 in growth promotion and management of banded leaf and sheath blight in maize seedling. Microbiol. Res. 2018, 214, 8–18. [Google Scholar] [CrossRef] [PubMed]
- Zhao, K.; Penttinen, P.; Zhang, X.; Ao, X.; Liu, M.; Yu, X.; Chen, Q. Maize rhizosphere in Sichuan, China, hosts plant growth promoting Burkholderia cepacia with phosphate solubilizing and antifungal abilities. Microbiol. Res. 2014, 169, 76–82. [Google Scholar] [CrossRef] [PubMed]
- Esmaeel, Q.; Pupin, M.; Jacques, P.; Leclère, V. Nonribosomal peptides and polyketides of Burkholderia: New compounds potentially implicated in biocontrol and pharmaceuticals. Environ. Sci. Pollut. Res. 2018, 25, 29794–29807. [Google Scholar] [CrossRef] [PubMed]
- Kandel, S.L.; Firrincieli, A.; Joubert, P.M.; Okubara, P.A.; Leston, N.D.; McGeorge, K.M. An in vitro study of bio-control and plant growth promotion potential of Salicaceae endophytes. Front. Microbiol. 2017, 8, 386. [Google Scholar] [CrossRef] [PubMed]
- Vandamme, P.; Dawyndt, P. Classification and identification of the Burkholderia cepacia complex: Past, present and future. Syst. Appl. Microbiol. 2011, 34, 87–95. [Google Scholar] [CrossRef] [PubMed]
- Yabuuchi, E.; Kosako, Y.; Oyaizu, H.; Yano, I.; Hotta, H.; Hashimoto, Y.; Ezaki, T.; Arakawa, M. Proposal of Burkholderia gen. nov. and transfer of seven species of genus Pseudomonas homology group II to the new genus, with the type species Burkholderia cepacia (Palleroni and Holmes, 1981) comb. nov. Microbiol. Immunol. 1992, 36, 1251–1275. [Google Scholar] [PubMed]
- Estrada-de los Santos, P.; Palmer, M.; Chávez-Ramírez, B.; Beukes, C.; Steenkamp, E.; Briscoe, L. Whole Genome Analyses Suggests that Burkholderia sensu lato Contains Two Additional Novel Genera (Mycetohabitans gen. nov., and Trinickia gen. nov.): Implications for the Evolution of Diazotrophy and Nodulation in the Burkholderiaceae. Genes 2018, 9, 389. [Google Scholar] [CrossRef] [PubMed]
- Coenye, T.; Vandamme, P.; Govan, J.R.; LiPuma, J.J. Taxonomy and identification of the Burkholderia cepacia complex. J. Clin. Microbiol. 2001, 39, 3427–3436. [Google Scholar] [CrossRef] [PubMed]
- Spilker, T.; Baldwin, A.; Bumford, A.; Dowson, C.G.; Mahenthiralingam, E.; LiPuma, J.J. Expanded multilocus sequence typing for Burkholderia species. J. Clin. Microbiol. 2009, 47, 2607–2610. [Google Scholar] [CrossRef] [PubMed]
- Fila, L.; Dřevínek, P. Burkholderia cepacia complex in cystic fibrosis in the post-epidemic period: Multilocus sequence typing-based approach. Folia Microbiol. 2017, 62, 509–514. [Google Scholar] [CrossRef] [PubMed]
- Yoder-Himes, D.R.; Chain, P.S.G.; Zhu, Y.; Wurtzel, O.; Rubin, E.M.; Tiedje, J.M.; Sorek, R. Mapping the Burkholderia cenocepacia niche response via high-throughput sequencing. Proc. Natl. Acad. Sci. USA 2009, 106, 3976–3981. [Google Scholar] [CrossRef] [PubMed]
- Goenadi, D.H.; Sisweto, I.; Sugiarto, Y. Bioactivation of poorly soluble phosphate rocks with a phosphorus- solubilizing fungus. Soil Sci. Soc. Am. J. 2000, 64, 927–932. [Google Scholar]
- Mahamuni, S.V. Anticeratocystis paradoxa and Alternaria alternata attribute of Burkholderia cenocepacia strain vimp 01 (jq867371). Int. J. Bioassays 2015, 4, 4290–4295. [Google Scholar]
- Otieno, N.; Lally, R.D.; Kiwanuka, S.; Lloyd, A.; Ryan, D.; Germaine, K.J.; Dowling, D.N. Plant growth promotion induced by phosphate solubilizing endophytic Pseudomonas isolates. Front. Microbiol. 2015, 6, 745. [Google Scholar] [CrossRef] [PubMed]
- Shahid, M.; Hameed, S.; Tariq, M.; Zafar, M.; Ali, A.; Ahmad, N. Characterization of mineral phosphate-solubilizing bacteria for enhanced sunflower growth and yield-attributing traits. Ann. Microbiol. 2015, 65, 1525–1536. [Google Scholar] [CrossRef]
- Taurian, T.; Anzuay, M.S.; Angelini, J.G.; Tonelli, M.L.; Ludueña, L.; Pena, D.; Ibáñez, F.; Fabra, A. Phosphate-solubilizing peanut associated bacteria: Screening for plant growth-promoting activities. Plant Soil 2010, 329, 421–431. [Google Scholar] [CrossRef]
- Dinesha, R.; Srinivasana, V.; Hamza, S.; Sarathambal, C.; Ankegowda, S.J.; Ganeshamurthy, A.N.; Gupta, S.B.; Nair, V.A.; Subila, K.P.; Lijina, A.; Divya, V.C. Isolation and characterization of potential Zn solubilizing bacteria from soil and its effects on soil Zn release rates, soil available Zn and plant Zn content. Geoderma 2018, 321, 173–186. [Google Scholar] [CrossRef]
- Cozzi, D.; Desidevi, P.G.; Lepri, L. The mechanism of ion exchange with algenic acid. J. Chromatogr. 1969, 40, 130–135. [Google Scholar] [CrossRef]
- Vaid, S.K.; Kumar, B.; Sharma, A.; Shukla, A.K.; Srivastava, P.C. Effect of Zn solubilizing bacteria on growth promotion and Zn nutrition of rice. J. Soil Sci. Plant Nutr. 2014, 14, 889–910. [Google Scholar] [CrossRef]
- Johnson-Beebout, S.E.; Lauren, J.G.; Duxbury, J.M. Immobilization of zinc fertilizer in flooded soils monitored by adapted DTPA soil test. Commun. Soil Sci. Plant Anal. 2009, 40, 1842–1861. [Google Scholar] [CrossRef]
- Natheer, S.E.; Muthukkaruppan, S. Assessing the in vitro zinc solubilization potential and improving sugarcane growth by inoculating Gluconacetobacter diazotrophicus. Ann. Microbiol. 2012, 62, 435–441. [Google Scholar] [CrossRef]
- Ong, K.S.; Lee, L.H.; Yule, C.M.; Cheow, Y.L.; Lee, S.M. Burkholderia paludis sp. nov. an antibiotic-siderophore producing novel Burkholderia cepacia Complex Species, isolated from Malaysian tropical peat swamp soil. Front. Microbiol. 2016, 7, 20–46. [Google Scholar] [CrossRef] [PubMed]
- Deng, P.; Wang, X.; Baird, S.M.; Showmaker, K.C.; Smith, L.; Peterson, D.G.; Lu, S. Comparative genome-wide analysis reveals that Burkholderia contaminans MS14 possesses multiple antimicrobial biosynthesis genes but not major genetic loci required for pathogenesis. MicrobiologyOpen 2016, 5, 353–369. [Google Scholar] [CrossRef] [PubMed]
- Hrynkiewicz, K.; Baum, C.; Leinweber, P. Density, metabolic activity and identity of cultivable rhizosphere bacteria on Salix viminalis in disturbed arable and landfill soils. J. Plant Nutr. Soil Sci. 2010, 173, 747–756. [Google Scholar] [CrossRef]
- Haas, D.; Défago, G. Biological control of soil-borne pathogens by fluorescent pseudomonads. Nat. Rev. Microbiol. 2005, 3, 307–319. [Google Scholar] [CrossRef] [PubMed]
- Vacheron, J.; Desbrosses, G.; Bouffaud, M.L.; Touraine, B.; Moënne-Loccoz, Y.; Muller, D. Plant growth-promoting rhizobacteria and root system functioning. Front. Plant Sci. 2013, 4, 356. [Google Scholar] [CrossRef] [PubMed]
- Khan, A.L.; Gilani, S.A.; Waqas, M.; Al-Hosni, K.; Al-Khiziri, S.; Kim, Y.H. Endophytes from medicinal plants and their potential for producing indole acetic acid, improving seed germination and mitigating oxidative stress. J. Zhejiang Univ.-SC B 2017, 18, 125–137. [Google Scholar] [CrossRef] [PubMed]
- Collavino, M.M.; Sansberro, P.A.; Mroginski, L.A.; Aguilar, O.M. Comparison of in vitro solubilization activity of diverse phosphate-solubilizing bacteria native to acid soil and their ability to promote Phaseolus vulgaris growth. Biol. Fertil. Soils 2010, 46, 727–738. [Google Scholar] [CrossRef]
- Onofre-Lemus, J.; Hernandez-Lucas, I.; Girard, L.; Caballero-Mellado, J. ACC (1-Aminocyclopropane-1-Carboxylate) deaminase activity, a widespread trait in Burkholderia species, and its growth-promoting effect on tomato plants. Appl. Environ. Microbiol. 2009, 75, 6581–6590. [Google Scholar] [CrossRef] [PubMed]
- Singh, R.P.; Shelke, G.M.; Kumar, A.; Jha, P.N. Biochemistry and genetics of ACC deaminase: A weapon to “stress ethylene” produced in plants. Front. Microbiol. 2015, 6, 937. [Google Scholar] [PubMed]
- Karthik, C.; Elangovan, N.; Kumar, T.S.; Govindharaju, S.; Barathi, S.; Oves, M.; Arulselvi, P.I. Characterization of multifarious plant growth promoting traits of rhizobacterial strain AR6 under Chromium (VI) stress. Microbiol. Res. 2017, 204, 65–71. [Google Scholar] [CrossRef] [PubMed]
- Hu, Q.P.; Xu, J.G.; Song, P.; Song, J.N.; Chen, W.L. Isolation and identification of a potential biocontrol agent Bacillus subtilis QM3 from Qinghai yak dung in China. World J. Microbiol. Biotechnol. 2008, 24, 2451–2458. [Google Scholar] [CrossRef]
- Ncube, E.; Flett, B.C.; Waalwijk, C.; Viljoen, A. Fusarium spp. and levels of fumonisins in maize produced by subsistence farmers in South Africa. S. Afr. J. Sci. 2011, 107, 1–7. [Google Scholar] [CrossRef]
- Matarese, F.; Sarrocco, S.; Gruber, S.; Seidl-Seiboth, V.; Vannacci, G. Biocontrol of Fusarium head blight: Interactions between Trichoderma and mycotoxigenic Fusarium. Microbiology 2012, 158, 98–106. [Google Scholar] [CrossRef] [PubMed]
- Axel, C.; Zannini, E.; Coffey, A.; Guo, D.M.; Arendt, E.K. Ecofriendly control of potato late blight causative agent and the potential role of lactic acid bacteria: A review. Appl. Microbiol. Biotechnol. 2012, 96, 37–48. [Google Scholar] [CrossRef] [PubMed]
- Maleki, M.; Mokhtarnejad, L.; Mostafaee, S. Screening of rhizobacteria for biological control of cucumber root and crown rot caused by Phytophthora drechsleri. Plant Pathol. J. 2011, 27, 78–84. [Google Scholar] [CrossRef]
- 50Tomioka, K.; Sato, T. Fruit rot of sweet pepper caused by Stemphylium lycopersici in Japan. J. Gen. Plant Pathol. 2011, 77, 342–344. [Google Scholar]
- Kurose, D.; Hoang, L.H.; Furuya, N.; Takeshita, M.; Sato, T.; Tsushima, S.; Tsuchiya, K. Pathogenicity of Stemphylium lycopersici isolated from rotted tobacco seeds on seedlings and leaves. J. Gen. Plant Pathol. 2014, 80, 147–152. [Google Scholar] [CrossRef]
- Nasehi, A.; Kadir, J.; Nasr-Esfahani, M.; Abed-Ashtiani, F.; Golkhandan, E.; Ashkani, S. Identification of the new pathogen (Stemphylium lycopersici) causing leaf spot on Pepino (Solanum muricatum). J. Phytopathol. 2016, 164, 421–426. [Google Scholar] [CrossRef]
- Torres, M.J.; Brandan, C.P.; Sabaté, D.C.; Petroselli, G.; Erra-Balsells, R.; Audisio, M.C. Biological activity of the lipopeptide-producing Bacillus amyloliquefaciens PGPBacCA1 on common bean Phaseolus vulgaris L. pathogens. Biol. Control 2017, 105, 93–99. [Google Scholar] [CrossRef]
- Soonthornpoct, P.; Trevathan, L.E.; Ingram, D. The colonization of maize seedling roots and rhizosphere by Fusarium spp. in Mississippi in two soil types under conventional tillage and notillage systems. Phytoprotection 2000, 81, 97–106. [Google Scholar] [CrossRef]
- Robles-Barrios, K.F.; Medina-Canales, M.G.; Rodríguez-Tovar, A.V.; Pérez, N.O. Morphological and molecular characterization, enzyme production and pathogenesis of Fusarium temperatum on corn in Mexico. Can. J. Plant Pathol. 2015, 37, 495–505. [Google Scholar] [CrossRef]
- Pal, K.K.; Tilak, K.V.B.R.; Saxcna, A.K.; Dey, R.; Singh, C.S. Suppression of maize root diseases caused by Macrophomina phaseolina, Fusarium moniliforme and Fusarium graminearum by plant growth promoting rhizobacteria. Microbiol. Res. 2001, 156, 209–223. [Google Scholar] [CrossRef] [PubMed]
- Heungens, K.; Parke, J.L. Zoospore homing and infection events: Effects of the biocontrol bacterium Burkholderia cepacia AMMDR1 on two oomycete pathogens of pea (Pisum sativum L.). Appl. Environ. Microb. 2000, 66, 5192–5200. [Google Scholar] [CrossRef]
- Omar, I.; O’neill, T.M.; Rossall, S. Biological control of Fusarium crown and root rot of tomato with antagonistic bacteria and integrated control when combined with the fungicide carbendazim. Plant Pathol. 2006, 55, 92–99. [Google Scholar] [CrossRef]
- Desjardins, A.E.; Plattner, R.D.; Nelsen, T.C.; Leslie, J.F. Genetic analysis of fumonisin production and virulence of Gibberella fujikuroi mating population A (Fusarium moniliforme) on maize (Zea mays) seedlings. Appl. Environ. Microbiol. 1995, 61, 79–86. [Google Scholar] [PubMed]
- Scauflaire, J.; Gourgue, M.; Callebaut, A.; Munaut, F. Fusarium temperatum, a mycotoxin-producing pathogen of maize. Eur. J. Plant Pathol. 2012, 133, 911–922. [Google Scholar] [CrossRef]
- Kifle, M.H.; Laing, M.D. Isolation and screening of bacteria for their diazotrophic potential and their influence on growth promotion of maize seedlings in greenhouses. Front. Plant Sci. 2016, 6, 1225. [Google Scholar] [CrossRef] [PubMed]
- Ho, Y.N.; Chiang, H.M.; Chao, C.P.; Su, C.C.; Hsu, H.F.; Guo, C.T. In planta biocontrol of soilborne Fusarium wilt of banana through a plant endophytic bacterium, Burkholderia cenocepacia 869T2. Plant Soil 2015, 387, 295–306. [Google Scholar] [CrossRef]
- Ho, Y.N.; Huang, C.C. Draft genome sequence of Burkholderia cenocepacia strain 869T2; a plant-beneficial endophytic bacterium. Genome Announc. 2015, 3, e01327-15. [Google Scholar] [CrossRef] [PubMed]
- Lane, D.J. 16S/23S rRNA sequencing. In Nucleic Acid Techniques in Bacterial Systematics; Stackebrandt, E., Goodfellow, M., Eds.; Wiley & Sons: Chichester, UK, 1991; pp. 132–175. [Google Scholar]
- Kimura, M. A simple method for estimating evolutionary rate of base substitution through comparative studies of nucleotide sequences. J. Mol. Evol. 1980, 16, 111–120. [Google Scholar] [CrossRef] [PubMed]
- Tamura, K.; Stecher, G.; Peterson, D.; Filipski, A.; Kumar, S. MEGA6: Molecular evolutionary genetics analysis version 6.0. Mol. Biol. Evol. 2013, 30, 2725–2729. [Google Scholar] [CrossRef] [PubMed]
- Cappuccino, J.G.; Sherman, N. Microbiology: A Laboratory Manual; The Benjamin/Cummings Publishing Co., Inc.: Menlo Park, CA, USA, 1996; pp. 491–496. [Google Scholar]
- Gordon, S.A.; Weber, R.P. Colorimetric estimation of indoleacetic acid. Plant Physiol. 1951, 26, 192–195. [Google Scholar] [CrossRef]
- Naik, P.R.; Sahoo, N.; Goswami, D.; Ayyadurai, N.; Sakthivel, N. Genetic and functional diversity among fluorescent psedumonas isolated from the rhizosphere of banana. Microb. Ecol. 2015, 56, 492–504. [Google Scholar] [CrossRef] [PubMed]
- Liu, K.; Newman, M.; McInroy, J.A.; Hu, C.H.; Kloepper, J.W. Selection and assessment of plant growth-promoting rhizobacteria for biological control of multiple plant diseases. Phytopathology 2017, 107, 928–936. [Google Scholar] [CrossRef] [PubMed]
- Wheeler, B.E.J. An Introduction to Plant Diseases; Wiley and Sons Ltd.: London, UK, 1969; p. 374. [Google Scholar]
- SAS Institute Inc. SAS/STAT® 9.2 User’s Guide; Institute Inc.: Cary, NC, USA, 2008. [Google Scholar]
© 2019 by the authors. Licensee MDPI, Basel, Switzerland. This article is an open access article distributed under the terms and conditions of the Creative Commons Attribution (CC BY) license (http://creativecommons.org/licenses/by/4.0/).